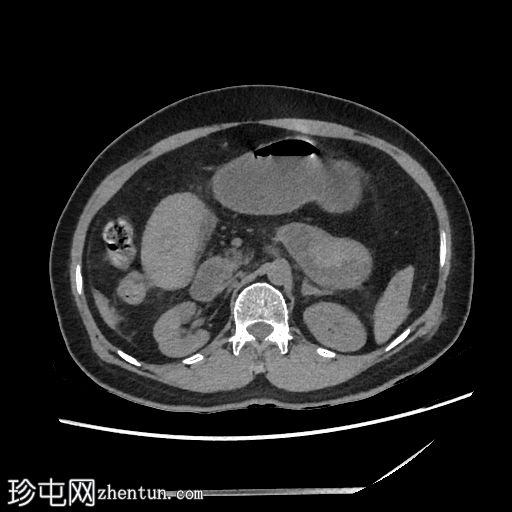
1.jpg

临床表现
患者主诉急性腹痛。既往有机械二尖瓣置换史,目前服用辛妥昔单抗(Sintrom)进行抗凝治疗。
患者资料
年龄:55岁
性别:女
CT
轴位
平扫

矢状位增强扫描
动脉期

轴位增强扫描
动脉期
空肠(长段,60 cm)肠壁弥漫性节段性增厚。肠壁呈高密度影,平扫CT值约为56 HU,并可见强化。
可见肠系膜水肿和血管充血,以及少量腹水。
肠系膜上动脉和静脉通畅,未见血栓。
影像学表现最提示黏膜下出血。
鉴别诊断包括感染性肠炎。
一天后
CT
轴位
非增强

轴位增强
动脉期

轴位增强
门静脉期

肠壁强化减弱,高度提示肠缺血。
腹腔内可见中等量腹水。
低灌注综合征:
血管表现
腹主动脉管径变细:前后径12 mm
腹主动脉分支变细:腹腔干5.3 mm;肝总动脉3.2 mm;脾动脉1.5 mm;肠系膜动脉直径 4.4 mm
下腔静脉扁平征
内脏表现
脾脏灌注不足,脾脏体积略有缩小:初始测量值为 57 x 35 x 38 mm,后续影像学检查缩小至 56 x 31 x 33 mm
肝脏灌注不足:肝实质呈不均匀强化,主要累及右肝叶
双侧肾上腺强化
双侧可见肾图增高、延长且呈条纹状
病例讨论
患者有机械二尖瓣置换史,并正在服用抗凝药物。
影像学表现提示自发性空肠壁内出血,伴有肠壁缺血的证据,导致出血性休克和弥漫性血管痉挛。CT 扫描期间,患者正在接受血管加压药物支持。
红细胞计数:1,77。血红蛋白:54 克/升。红细胞压积:16.4%。
国际标准化比值:28.3。 |